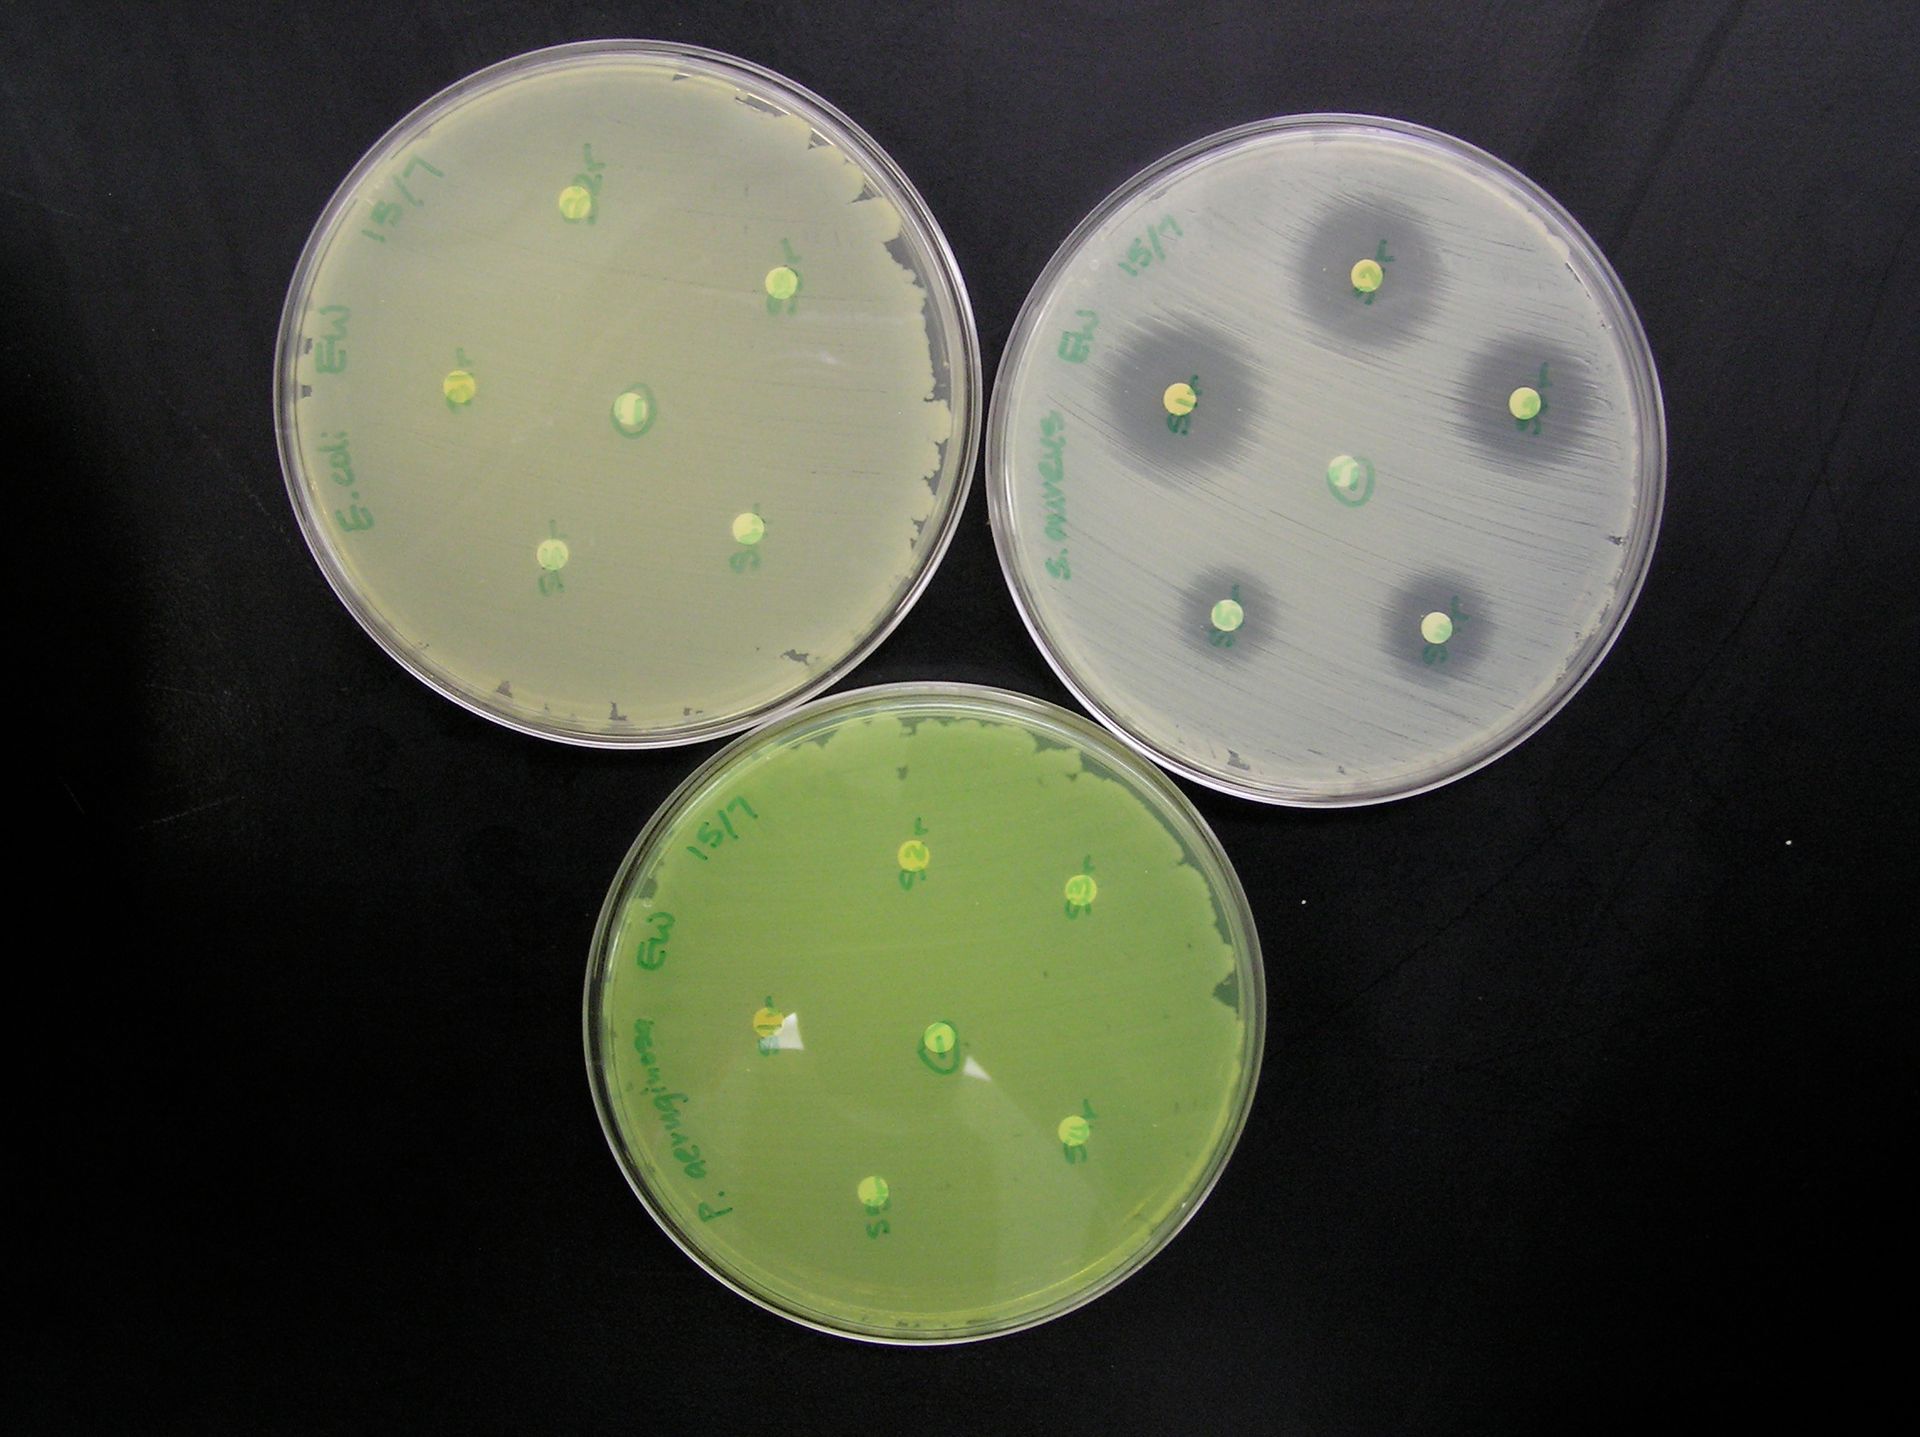

Philosophy
Research Philosophy – What, How, Who
Research is, for me, an intensely sacred calling that winds through inspiration, revelation and imagination. It is a journey of curiosity and discovery as implied by the Middle French root word – recherche – ‘to go about seeking.’ I believe the attitude of a relentless researcher is eternally embedded in the Old Testament archetype of Jacob wrestling and in the New Testament text ‘Ask, and it shall be given unto you; seek, and ye shall find; knock, and it shall be opened unto you.’ In addition, Emily Dickinson’s poem tagline, ‘This World is Not Conclusion” expresses a powerful reason ‘to go about seeking.’
For me, there are three fundamental questions or considerations in thinking about and conducting research: “what,” “how,” and “who.” As a synthetic organic chemist my “what” generally lies within the field of synthetic methodology. My “how” prioritizes the following general considerations: green chemistry, and novel, bio-inspired juxtapositioning of organic functional groups in small molecules and investigation of their unique emergent chemical, physical and biological properties.

This bio-inspired approach is based on the simple observation that most classes of important biological molecules – amino acids, nucleic acids, carbohydrates – contain functional groups with unique relative regiochemistry. The functional group arrangements found in these natural molecules result in several important emergent properties including: (1) increased molecular complexity, (2) unique molecular and macromolecular biological structures, (3) specific and sequential biochemical reactions and pathways, and (4) critical biological functions. This approach to organic synthesis incorporates both curiosity driven and translational focused research.
Just as important is the question of “who.” This ‘broader impact’ consideration is generally what has driven my cross-demographic early research initiatives at both the high school and college levels. It proactively seeks, promotes and provides early engagement in research for all God’s children, without regard to race, gender, ethnicity, nationality, educational background, or socioeconomic status, in one of the most consequential adventures known to humans. My vision is universal adoption of early engagement.
Our BEST Early motto: People First, Innovate Early captures this spirit, philosophy, and approach. Simply put, we believe that students do not require four years of high school and four years of college before they are engaged in authentic research. There is no valid reason why students who drive cars, use computers, excel at video games, and navigate a host of modern twenty-first century technologies cannot be also trained to recrystallize solids, rotovap solvents, reflux reactions, separate mixtures, or even operate infrared, Raman, UV-Vis or NMR instruments. For example, with Co-PI Dr. Denise Smith, I co-developed a year-long interdisciplinary (chemistry-biology) course-based high school independent research experience for Grade 12 students.
Since 1998, I have designed, developed, and implemented course-based undergraduate research experiences (CURE) as a vehicle to provide opportunity and engage students in ‘early and often,’ ‘hands-on, minds-on’ authentic interdisciplinary and inter-level research. Based on this consideration I established a federal 501(c) (3) nonprofit organization called Building Excellence in Science and Technology (BEST Early) to engage both high school and college students in original chemical research. This research-pedagogical approach addresses the national problem of underrepresentation and underfunding of early researchers in the research and STEM enterprises.
Teaching Philosophy and Practice
Have you ever observed people's expression upon learning that you have a Ph.D. in Chemistry? Frequently, their anguished expression is followed by horror stories of a chemistry class, lab or teacher from hell or all three! I believe that my role as a teacher is to ‘inspire others’ by my actions, not just words, ‘to dream more, learn more, do more and become more,’ and in so doing reduce the ‘activation barrier’ that many seem to experience just by the mere mention of the word chemistry.
During over 30 years of teaching, that goes back to a one-year high school teaching stint (1980 – 1981) before entering college, I approach teaching not simply as a job but as my calling, vocation and mission. In fact, I recall my two childhood ambitions and life dreams were to be a scientist and a teacher. I bring to the classroom, lab and community a passion to inspire others, nurture dreams, increase their knowledge and allow them to ‘become more’ than when they first walked into class.
The key elements of my teaching philosophy and practice that seek to increase knowledge and inspire learners are: (a) contextual pedagogy, (b) encouraging inquiry and critical thinking, (c) early research, (d) interlevel collaborations, and (e) public engagement.

Excerpts of testimonials of three students and two former Andrews University Chemistry faculty show my commitment to mentoring, teaching, and inspiring:
- Brendaliz Moris wrote, “Dr. Murray was a very approachable and lighthearted instructor who made the research environment enjoyable and unintimidating. I appreciated the time he dedicated to personally instructing me, always encouraging curiosity.”
- Jalen Stallard wrote, “Beyond the curriculum, he created a safe, nurturing environment that fostered not only academic growth but personal development. His accessibility, consistent monitoring, and willingness to answer even the smallest questions made me feel supported as a human being first. This environment proved critical for my development, extending far beyond the confines of the classroom. His mentorship was bigger than teaching; it was about building character and confidence in a space that felt secure and educational.”
- Gabriella Francisco wrote, “When I look back on my time at Andrews, there’s no doubt in my mind that Dr. Murray was the one person who consistently looked out for me and genuinely wanted the best for my future. I can say with full confidence that he is an exceptional professor, mentor, and friend.”
- Peter Wong, former Andrews University Chemistry Professor wrote, “You have contributed much to the Department. As a result of your passion for student research at an early year of academic life, you have put Andrews University on the map in Michigan. I also admire your enthusiasm with getting speakers from all over the country to speak in the Chemistry Seminar. No one before you have attempted to do anything like that.”
- Bill Mutch, former Chair, Department of Chemistry and Biochemistry, wrote after attending a few of my students’ research oral presentations: “I was impressed with the quality of the presentations, the level of understanding of the work they're planning to do, and the enthusiasm for working on the projects.”
Diversity
Diversity is elemental. 118 of them. From hydrogen to oganesson. It is natural, it is synthetic too; it is foundational to chemistry and life; to new materials, new life-saving drugs, to matter in service of our humanity. It is chemical. It is our future, our imagination, and our endless possibilities. The work of diversity will continue; it will last, beyond you, beyond me.
I was born in the postcolonial multicultural, multiethnic, and multireligious Caribbean nation of Trinidad and Tobago. My early years were marked by diversity, equity, inclusion, respect and belonging in my lived educational, social, and religious experiences. This is aptly expressed in the national anthem of Trinidad and Tobago which says in part, “here every creed and race find an equal place.”
One of the demographic areas of diversity that I have addressed focuses on expanding research opportunities and enhancing inclusion of high school, college underclassmen, and community college students in research. This was the driving force behind my (a) organization of the early research symposium at the 2014 Biennial Conference on Chemical Education, (b) leadership in producing the 2016 ACS Symposium Series book The Power and Promise of Early Research, and (c) founding of Building Excellence in Science and Technology (BEST Early), a federal nonprofit organization. The often-overlooked fact is that early researchers are an underrepresented demographic in numbers, participation, and funding in the American research ecosystem and enterprise. This represents an ongoing loss and waste of human resources, talent and opportunity and is fundamentally educational malpractice. Chapter 1 (Early Research: A Strategy for Inclusion and Student Success) of the above mentioned book deals with this in more detail.